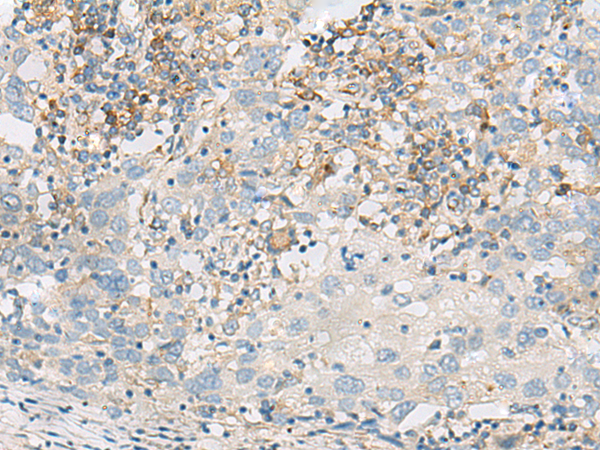
一抗

|
Background: |
Transcription factor that binds to the E-box and functions as inhibitor of transcription. DNA binding requires dimerization with an E protein. Inhibits transcription activation by ASCL1/MASH1 by sequestering E proteins (By similarity). |
|
Applications: |
ELISA, IHC |
|
Name of antibody: |
FERD3L |
|
Immunogen: |
Synthetic peptide of human FERD3L |
|
Full name: |
Fer3 like bHLH transcription factor |
|
Synonyms: |
PTFB; NATO3; NTWIST; N-TWIST; bHLHa31 |
|
SwissProt: |
Q96RJ6 |
|
ELISA Recommended dilution: |
5000-10000 |
|
IHC positive control: |
Human colorectal cancer and Human cervical cancer |
|
IHC Recommend dilution: |
50-300 |


 購物車
購物車 幫助
幫助
 021-54845833/15800441009
021-54845833/15800441009